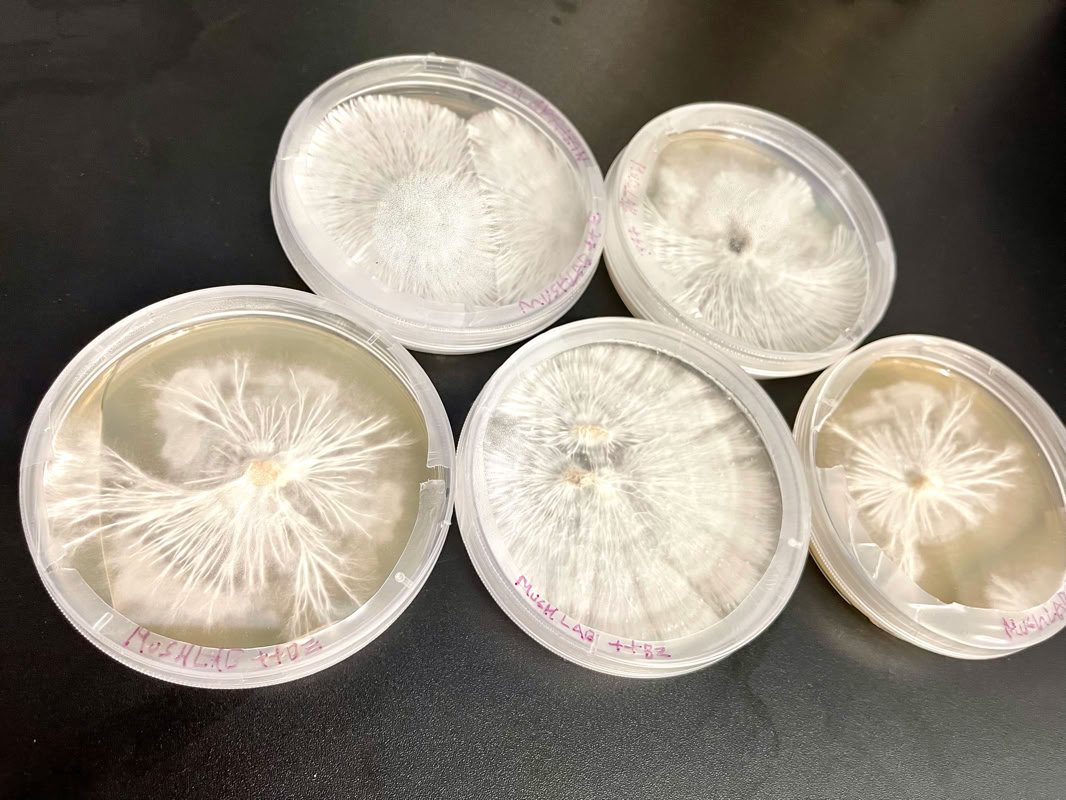
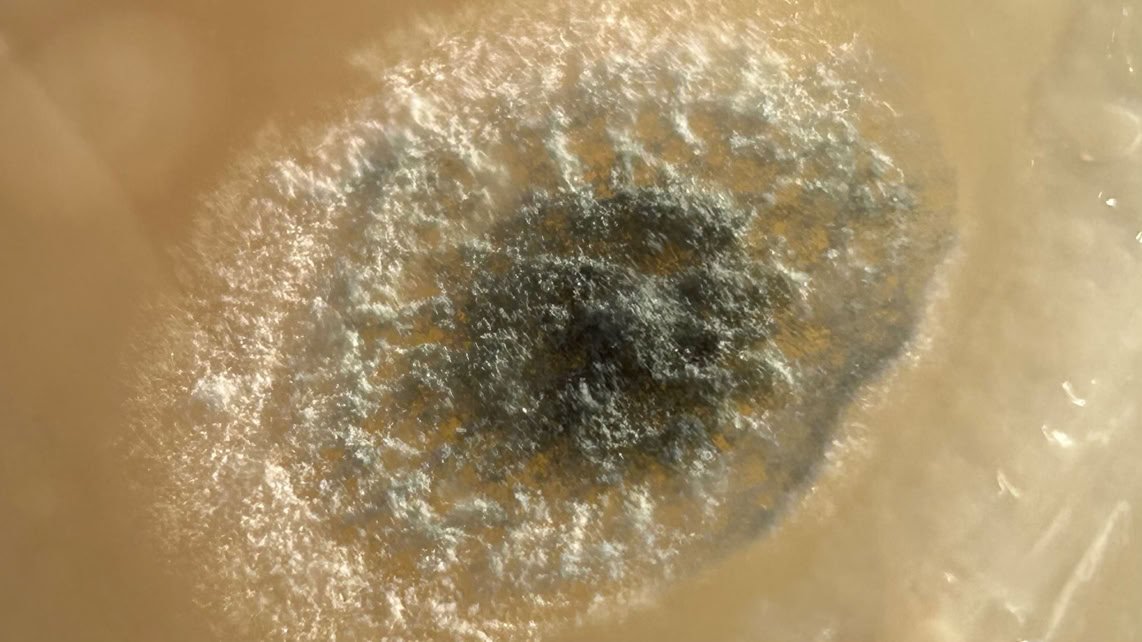
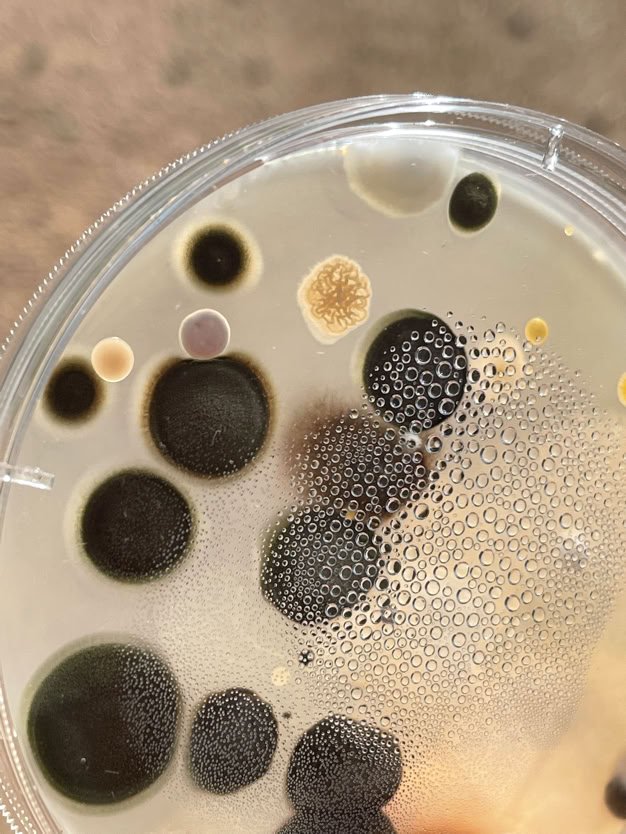

CLONING SERVICE
Clone your products on any growth medium, or choose our delicious growth medium.

Test your specimens on any medium, or choose from our fine selection of growth medium.
TISSUE SAMPLE PROPAGATION ISOLATION

INOCULATION SERVICE
Inculation of spores or slants onto your selection of medium, or choose our fine medium.
PROPAGATION & ISOLATION
Find what grows from your specimen samples and isolate these to be inoculated.
LABORATORY
AS A SERVICE
CLONING SERVICE
Copy your fresh isolated specimens onto a growth medium of your choice.

INOCULATION
Putting the specimen into an initially sterile environment that supports its growth. Specimen viability can be observed. The resulting healthy specimens can be used for “fruiting” the specimen and enjoying the experience of the specimens full lifecycle.
Collecting Data and Metrics
Every step of the process creates data that results in product improvements and quality management.

THIRD PARTY or LAW ENFORCEMENT SPECIMEN TESTING and VERIFICATION
IDENTITY REVEALED, PURPOSE IDENTIFIED
Contact us if you require additional third party test panels for evidence or court ordered proceedings.

niko@sunagainfarm.com
SUN AGAIN FARM LLC.
200 S Curtis Ave. #706
WILLCOX, AZ 85643-2144
(520) 425-4912
TEXT PREFERED, CALLS ARE SCREENED